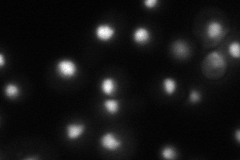
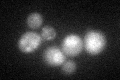

View description
Nucleosomal histone H3-Lys79 methylase; methylation is required for telomeric silencing, meiotic checkpoint control, and DNA damage response
Localization:
Intensity:
Fold change:
Significance:
-
C’ GFP library in SD

below threshold15.21 -
N' NOP1pr-GFP in SD

punctate,nucleus58.3897 -
N' TEF2pr-mCherry in SD
nucleus43.1546 -
N' NATIVEpr-GFP in SD

nucleus23.6693 -
N' TEF2pr-VC and Cyto-VN in SD

#N/A0 -
C’ GFP library in SD+DTT
cytosol17.171.12No -
C’ GFP library in SD+H2O2

cytosol16.81.1No -
C’ GFP library in Starvation Media

cytosol161.05No -
C’ GFP library on the background of Pup2-DaMP

below threshold -
C’ GFP library on the background of CCT mutant

below threshold16.52421.08563No
